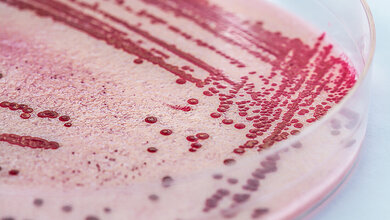
Listerien.jpg Listerien

Zoonosen in der EU auf dem Vormarsch
Die Zahl der gemeldeten Fälle von Listeria-Infektionen beim Menschen (2.952) stieg im Zeitraum 2019 bis 2023 kontinuierlich an und erreichte ihren Höchststand seit 2007. Dies könnte mit der alternden Bevölkerung in Europa zusammenhängen – 21,3 % der Europäerinnen und Europäer sind heute über 65 Jahre alt, was im Zusammenhang mit der zunehmenden Prävalenz chronischer altersbedingter Erkrankungen das Risiko schwerer Symptome in älteren Altersgruppen erhöht. Kontaminierte verzehrfertige Lebensmittel, wie zum Beispiel kaltgeräucherter Lachs, Fleischerzeugnisse und Milcherzeugnisse, sind dabei die häufigsten Infektionsquellen. Die neuesten Daten zeigen, dass der Anteil der Proben von verzehrfertigen Lebensmittelkategorien, die die Kontaminationsgrenzwerte für Listeria monocytogenes überschreiten, zwischen 0,11 % und 0,78 % liegt, wobei der höchste Wert für fermentierte Wurstwaren gemeldet wurde.
Campylobakteriose und Salmonellose
Campylobakteriose und Salmonellose waren in der EU die am häufigsten gemeldeten Zoonosen beim Menschen. Im Jahr 2023 wurden 148.181 Campylobakteriose-Fälle gemeldet, was einem Anstieg gegenüber den 139.225 Fällen im Jahr 2022 entspricht.
Nach der Campylobakteriose war die Salmonellose die am zweithäufigsten gemeldete gastrointestinale Infektion beim Menschen mit 77.486 Fällen, verglichen mit 65.478 Fällen im Jahr 2022. Nur 15 Mitgliedstaaten und das Vereinigte Königreich haben jedoch alle festgelegten Ziele für die Reduzierung von Salmonellen bei Geflügel erfolgreich erreicht. Dies entspricht einem Rückgang gegenüber 2022, als 19 Mitgliedstaaten alle Ziele erreicht hatten.
Instrumente der verstärkten Überwachung
„Die anhaltende Präsenz von Salmonellen in Geflügelpopulationen unterstreicht die Notwendigkeit ständiger Wachsamkeit bei der Bekämpfung von lebensmittelbedingten Erkrankungen. Instrumente der verstärkten Überwachung wie die Gesamtgenomsequenzierung sind von unschätzbarem Wert, wenn es darum geht, Ausbrüche wirksamer aufzudecken und zu kontrollieren“, so Frank Verdonck, Leiter des Referats "Biologische Gefahren und Tiergesundheit" der Europäischen Behörde für Lebensmittelsicherheit (EFSA) .
Darüber hinaus werden in dem Bericht lebensmittelbedingte Krankheitsausbrüche in der EU erfasst, das heißt Ereignisse, bei denen mindestens zwei Personen aufgrund desselben kontaminierten Lebensmittels dieselbe Erkrankung bekommen. Im Jahr 2023 wurden 5.691 lebensmittelbedingte Krankheitsausbrüche gemeldet; dies entspricht einem leichten Rückgang im Vergleich zum Vorjahr. Die Zahl der Infektionen beim Menschen, Krankenhauseinweisungen und Todesfälle stieg jedoch an, wobei die Zahl der Todesfälle den Höchststand seit einem Jahrzehnt erreichte. Salmonellen waren nach wie vor die Hauptursache für lebensmittelbedingte Krankheitsausbrüche, Fälle, Krankenhauseinweisungen und Todesfälle. Die häufigsten Ursachen von Ausbrüchen von Salmonellose waren Eier und Eiprodukte, gemischte Lebensmittel und Masthähnchenfleisch. Die verstärkte Nutzung der Gesamtgenomsequenzierung verbesserte die Sensibilität der Überwachung und die Fähigkeit, Ausbrüche in den Mitgliedstaaten, die sie umgesetzt haben, zu erkennen.
„Der Anstieg der schwerwiegenden Folgen von lebensmittelbedingten Krankheitsausbrüchen verdeutlicht die anhaltende Bedrohung der öffentlichen Gesundheit durch Salmonellen und andere mit Lebensmitteln übertragbare Krankheitserreger. Durch die Integration der Gesundheit von Mensch, Tier und Umwelt im Rahmen einer Strategie „Eine Gesundheit“ können wir die Ausbreitung dieser Erkrankungen besser verhindern und die öffentliche Gesundheit schützen“, so Celine Gossner, Leiterin der Abteilung „Neu auftretende, durch Lebensmittel und Vektoren übertragbare Krankheiten“ des Europäischen Zentrums für die Prävention und die Kontrolle von Krankheiten (ECDC).
Quelle: EFSA
Artikel teilen